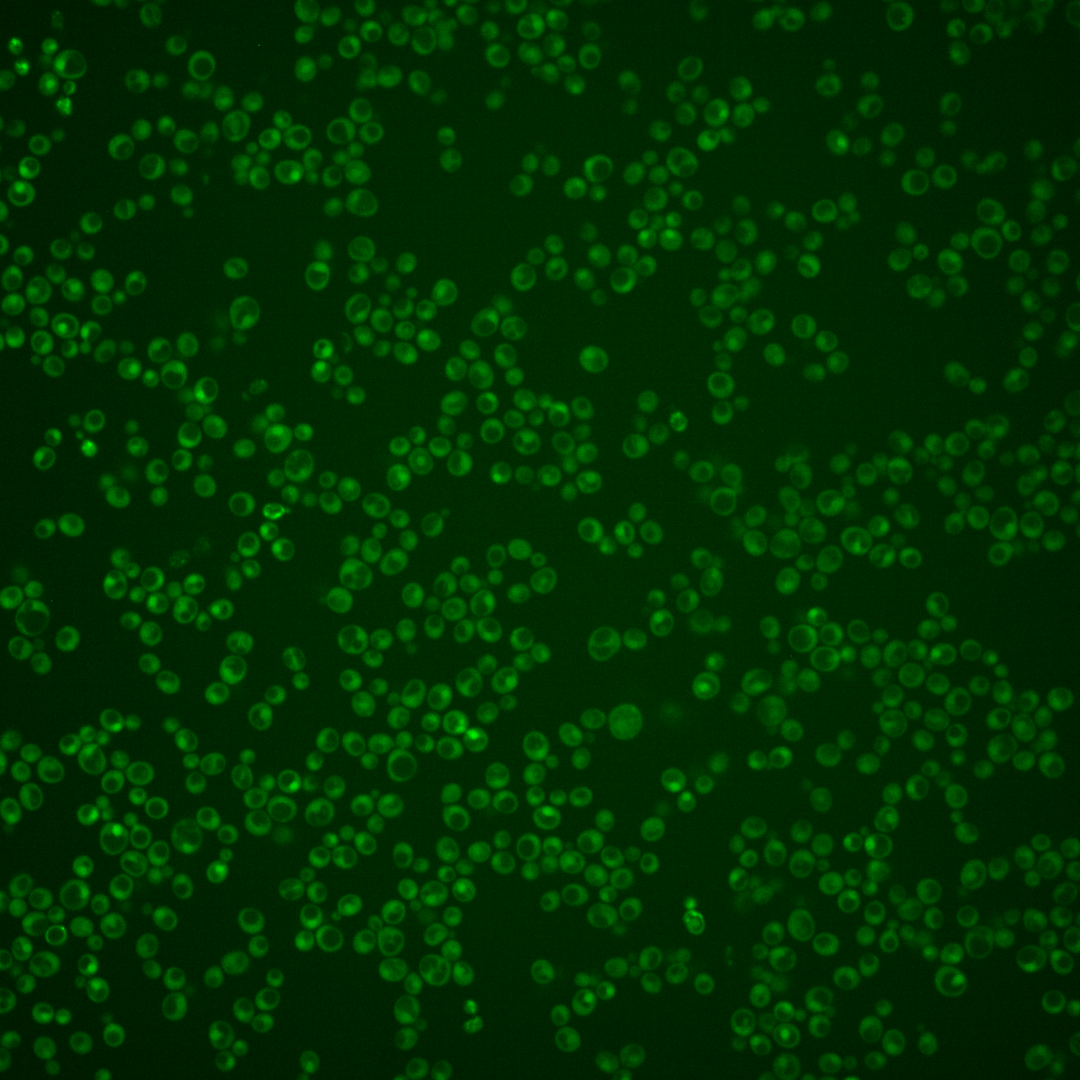
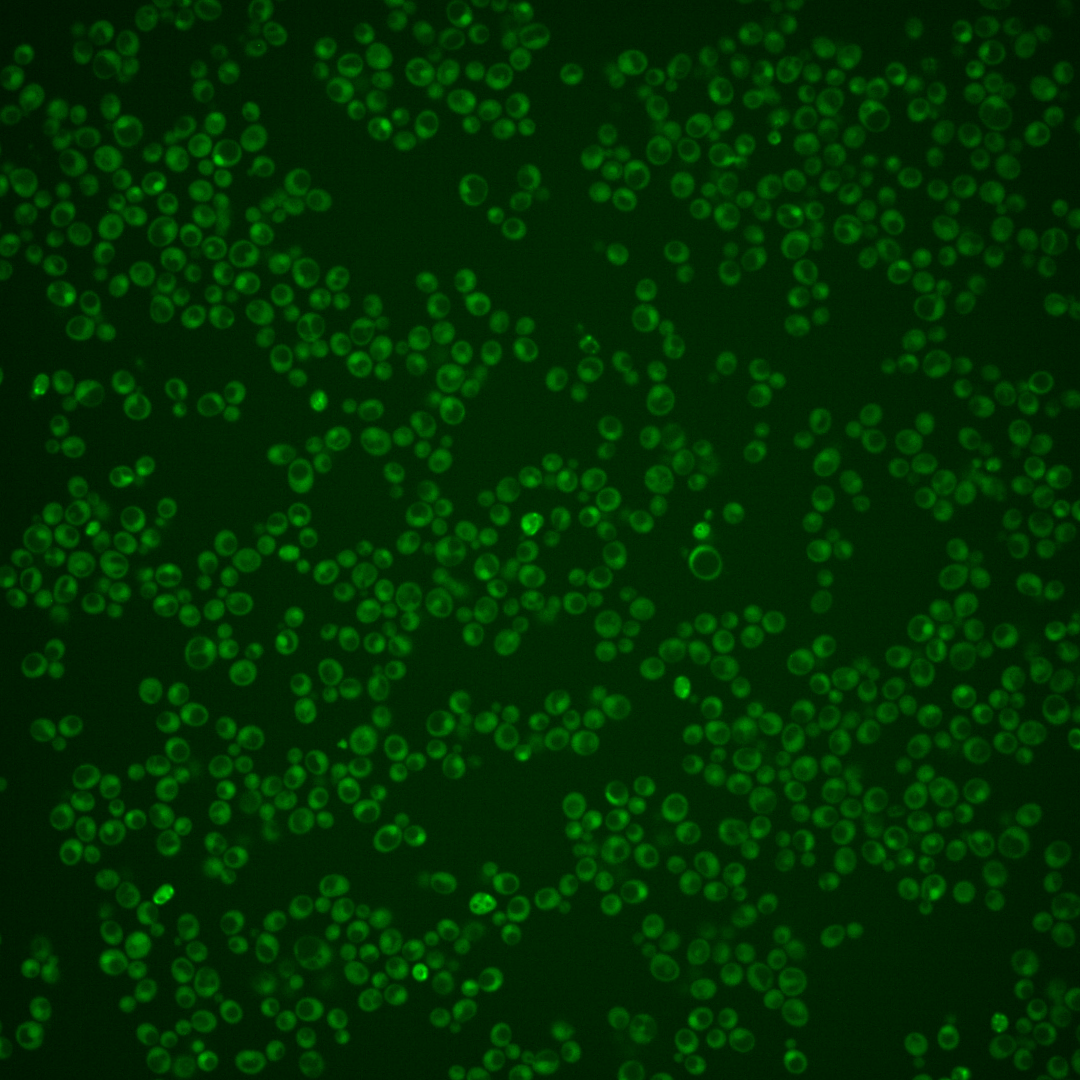
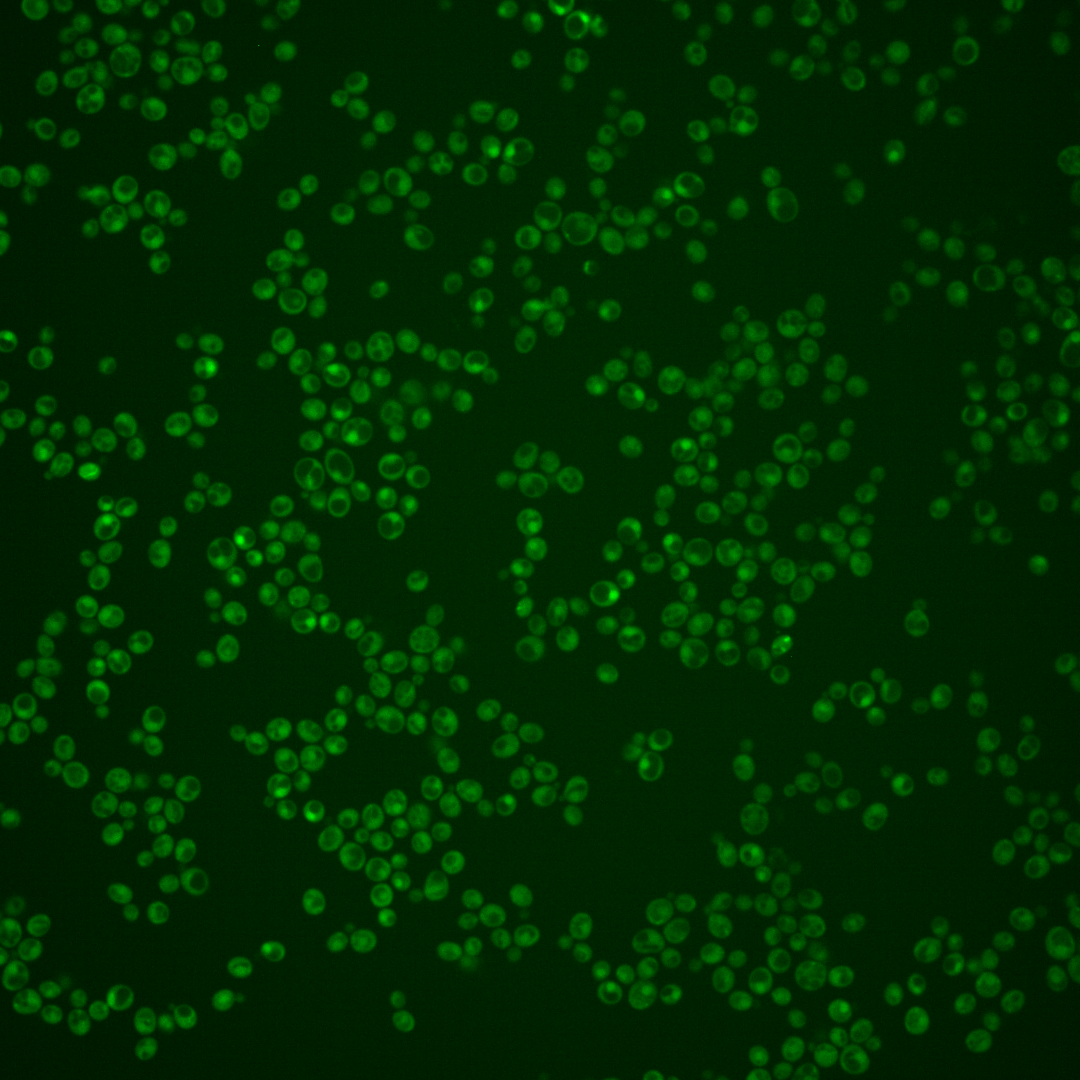
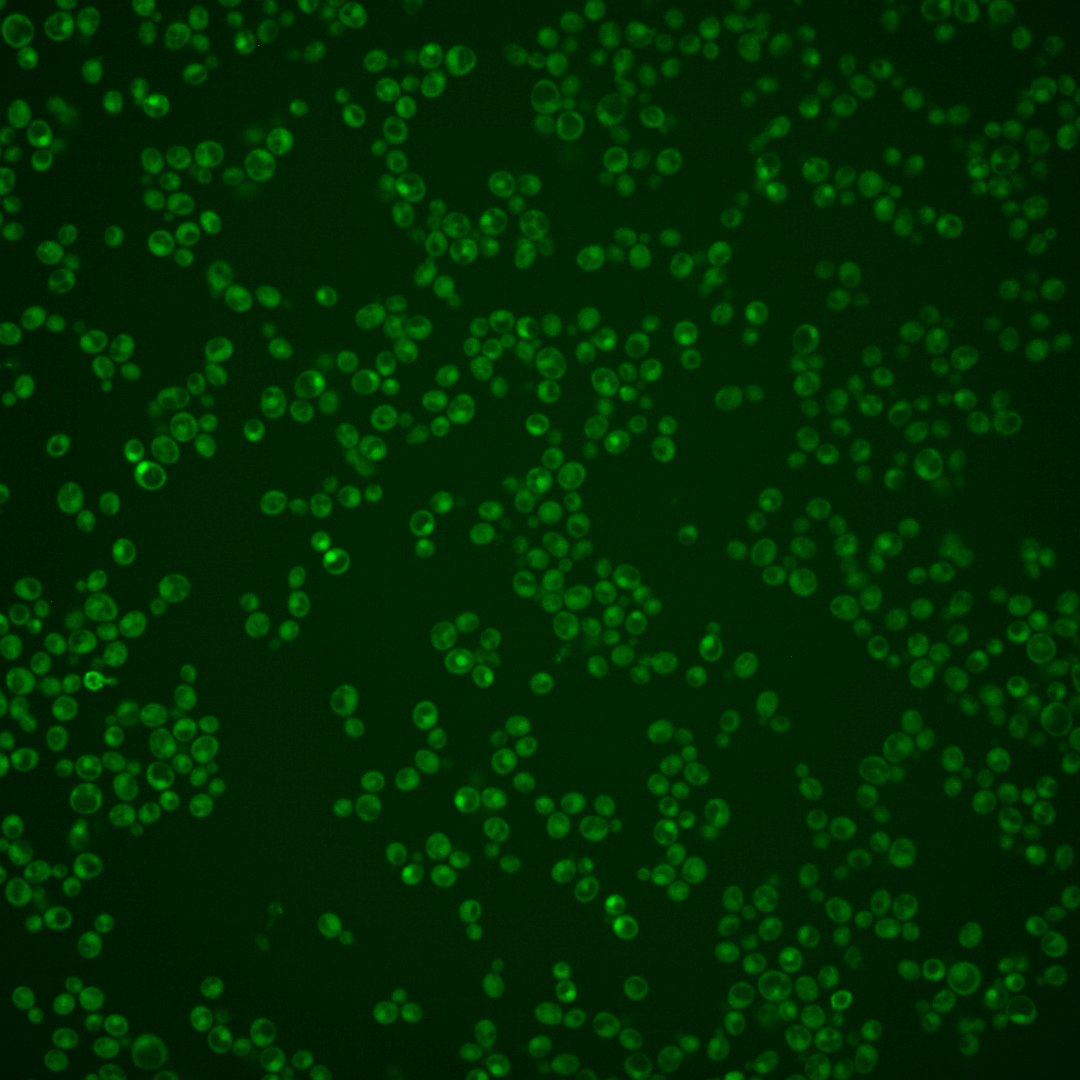
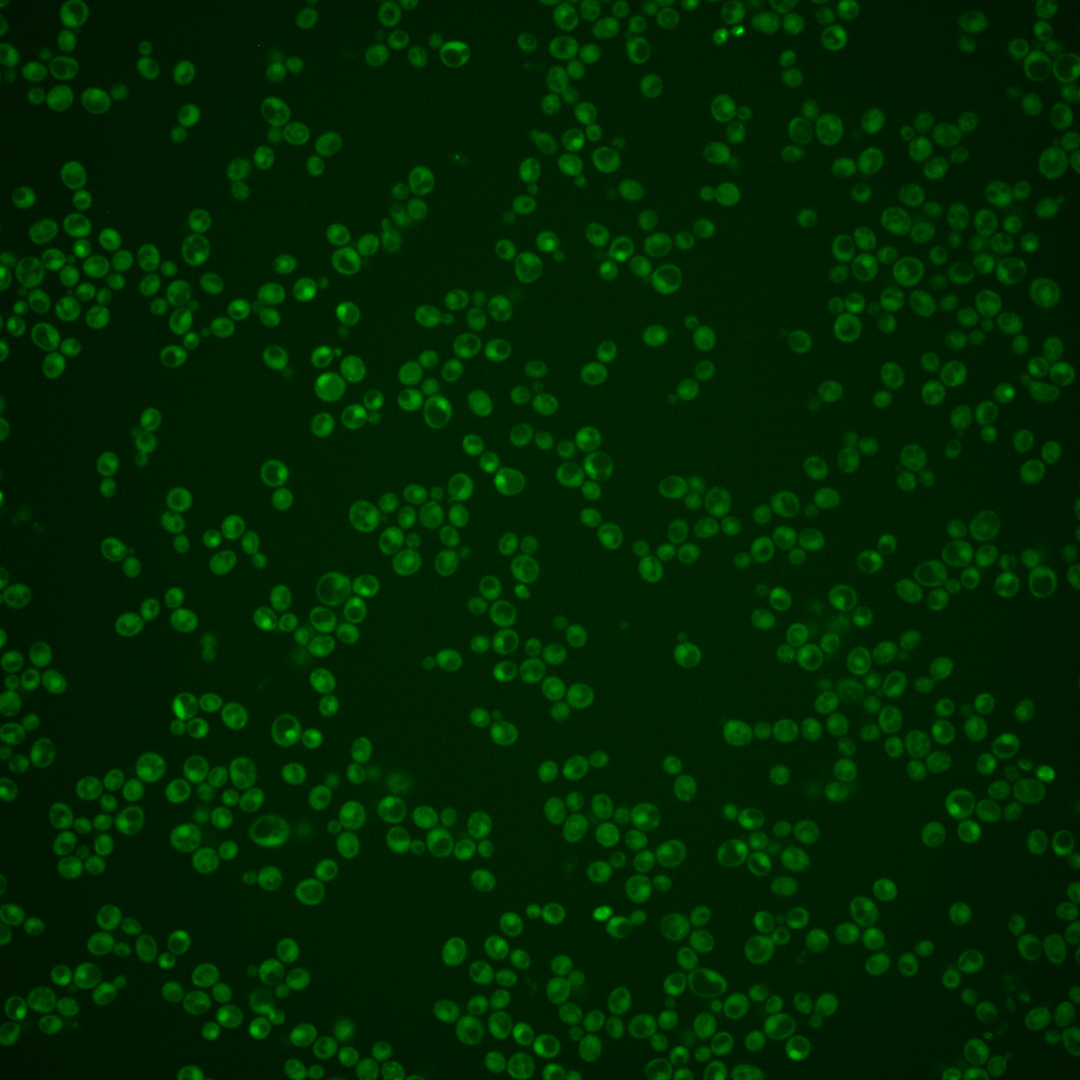
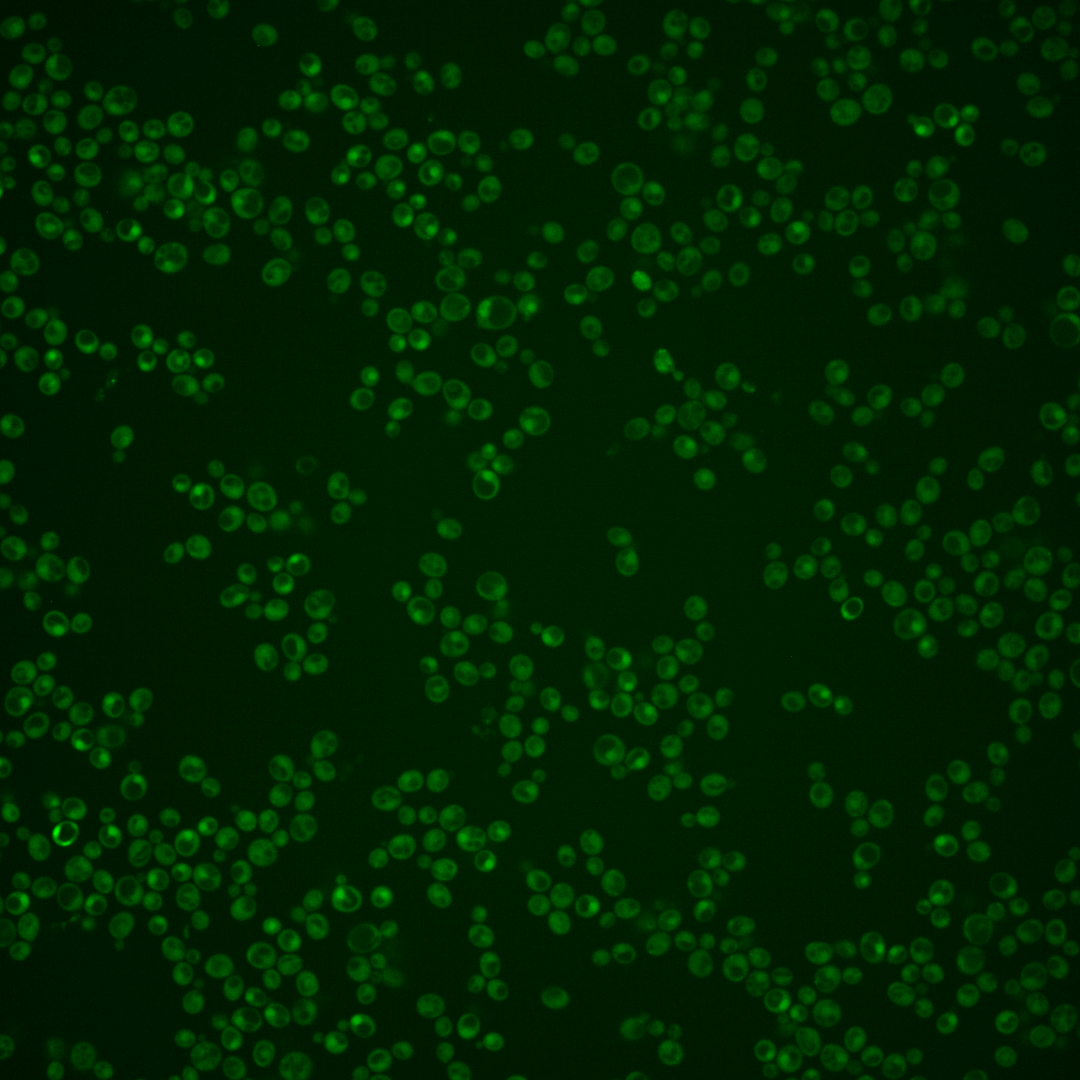

| Standard name | |
|---|---|
| Human Ortholog | |
| Description | Protein component of the synaptonemal complex axial elements; involved in chromosome segregation during the first meiotic division; critical for coupling checkpoint signaling to SC formation; promotes interhomolog recombination by phosphorylating Hop1p; also interacts with Mec3p and Ddc1p |
Micrographs




















































































Sub-cellular Localization
Yeast GFP Assignment
Protein Abundance
Localization Change
External localization resources
| ensLOC | DeepLoc | |||||||||||||||||||||||
|---|---|---|---|---|---|---|---|---|---|---|---|---|---|---|---|---|---|---|---|---|---|---|---|---|
| Localization | WT1 | WT2 | WT3 | RAP60 | RAP140 | RAP220 | RAP300 | RAP380 | RAP460 | RAP540 | RAP620 | RAP700 | HU80 | HU120 | HU160 | rpd3Δ_1 | rpd3Δ_2 | rpd3Δ_3 | WT1 | WT2 | WT3 | AF100 | AF140 | AF180 |
| Cortical Patches | 0 | 0 | 0 | 0 | 0 | 0 | 0 | 1 | 0 | – | 0 | 0 | 0 | 0 | 0 | 1 | 1 | 0 | 1 | 1 | 3 | 0 | 3 | 3 |
| Bud | 0 | 1 | 0 | 0 | 1 | 2 | 2 | 2 | 4 | – | 2 | 4 | 0 | 0 | 0 | 0 | 0 | 0 | 1 | 1 | 7 | 0 | 6 | 7 |
| Bud Neck | 1 | 1 | 10 | 7 | 14 | 6 | 5 | 10 | 8 | – | 1 | 8 | 0 | 0 | 0 | 0 | 2 | 0 | 0 | 0 | 1 | 0 | 3 | 2 |
| Bud Site | 0 | 0 | 0 | 0 | 0 | 0 | 0 | 0 | 1 | – | 1 | 2 | 0 | 0 | 0 | 0 | 0 | 0 | – | – | – | – | – | – |
| Cell Periphery | 3 | 2 | 1 | 2 | 2 | 0 | 4 | 3 | 1 | – | 0 | 0 | 0 | 1 | 2 | 1 | 1 | 0 | 1 | 1 | 5 | 0 | 3 | 3 |
| Cytoplasm | 189 | 302 | 492 | 332 | 503 | 328 | 455 | 362 | 258 | – | 142 | 208 | 114 | 331 | 321 | 232 | 198 | 169 | 174 | 280 | 338 | 57 | 252 | 154 |
| Endoplasmic Reticulum | 0 | 0 | 0 | 0 | 0 | 0 | 1 | 0 | 0 | – | 0 | 0 | 0 | 2 | 0 | 20 | 12 | 17 | 0 | 0 | 3 | 0 | 5 | 4 |
| Endosome | 0 | 0 | 0 | 0 | 0 | 1 | 0 | 0 | 0 | – | 0 | 1 | 0 | 0 | 0 | 19 | 5 | 11 | 0 | 3 | 4 | 0 | 2 | 2 |
| Golgi | 0 | 0 | 1 | 0 | 0 | 0 | 0 | 1 | 0 | – | 0 | 0 | 0 | 0 | 0 | 0 | 1 | 1 | 0 | 0 | 3 | 0 | 0 | 0 |
| Mitochondria | 2 | 9 | 2 | 4 | 6 | 34 | 52 | 21 | 80 | – | 59 | 55 | 9 | 0 | 0 | 6 | 8 | 8 | 5 | 8 | 29 | 3 | 29 | 20 |
| Nucleus | 1 | 0 | 5 | 5 | 2 | 1 | 4 | 5 | 3 | – | 3 | 7 | 0 | 0 | 0 | 81 | 71 | 52 | 0 | 0 | 1 | 0 | 1 | 0 |
| Nuclear Periphery | 0 | 0 | 0 | 0 | 0 | 0 | 0 | 0 | 0 | – | 0 | 0 | 0 | 0 | 0 | 1 | 0 | 0 | 0 | 0 | 2 | 0 | 0 | 0 |
| Nucleolus | 0 | 1 | 0 | 0 | 0 | 0 | 0 | 0 | 0 | – | 0 | 1 | 0 | 1 | 1 | 0 | 0 | 0 | 0 | 0 | 1 | 0 | 1 | 0 |
| Peroxisomes | 0 | 0 | 1 | 0 | 0 | 0 | 0 | 0 | 0 | – | 0 | 1 | 0 | 0 | 0 | 0 | 0 | 0 | 0 | 0 | 0 | 0 | 0 | 0 |
| SpindlePole | 0 | 0 | 2 | 0 | 3 | 3 | 5 | 5 | 0 | – | 2 | 6 | 0 | 0 | 0 | 2 | 1 | 2 | 0 | 4 | 7 | 0 | 5 | 0 |
| Vac/Vac Membrane | 1 | 0 | 1 | 1 | 1 | 1 | 1 | 0 | 3 | – | 1 | 3 | 0 | 0 | 1 | 115 | 96 | 88 | 4 | 3 | 4 | 1 | 12 | 17 |
| Unique Cell Count | 193 | 307 | 498 | 336 | 511 | 340 | 474 | 376 | 289 | 180 | 258 | 116 | 333 | 323 | 410 | 338 | 297 | 196 | 308 | 438 | 68 | 333 | 222 | |
| Labelled Cell Count | 197 | 316 | 515 | 351 | 532 | 376 | 529 | 410 | 358 | 211 | 296 | 123 | 335 | 325 | 478 | 396 | 348 | 196 | 308 | 438 | 68 | 333 | 222 | |
Yeast GFP Assignment
Protein Abundance
| Screen | WT1 | WT2 | WT3 | RAP60 | RAP140 | RAP220 | RAP300 | RAP380 | RAP460 | RAP540 | RAP620 | RAP700 | HU80 | HU120 | HU160 | rpd3Δ_1 | rpd3Δ_2 | rpd3Δ_3 | AF100 | AF140 | AF180 |
|---|---|---|---|---|---|---|---|---|---|---|---|---|---|---|---|---|---|---|---|---|---|
| Mean Cell GFP Intensity (1e-4) | 3.6 | 4.0 | 4.8 | 4.3 | 4.9 | 3.8 | 4.2 | 4.5 | 3.4 | – | 3.1 | 3.6 | 4.1 | 4.2 | 4.3 | 6.4 | 6.6 | 6.1 | 4.0 | 3.9 | 4.4 |
| Std Deviation (1e-4) | 0.5 | 0.6 | 1.3 | 1.5 | 1.7 | 1.5 | 1.5 | 1.8 | 1.2 | – | 0.7 | 0.9 | 1.6 | 1.2 | 1.6 | 1.2 | 1.3 | 1.1 | 1.7 | 1.3 | 1.8 |
| Intensity Change (Log2) | – | – | – | -0.13 | 0.03 | -0.32 | -0.2 | -0.09 | -0.51 | – | -0.64 | -0.41 | -0.21 | -0.18 | -0.14 | 0.42 | 0.46 | 0.35 | -0.24 | -0.29 | -0.11 |
Localization Change
| Localization | RAP60 | RAP140 | RAP220 | RAP300 | RAP380 | RAP460 | RAP540 | RAP620 | RAP700 | HU80 | HU120 | HU160 | rpd3Δ_1 | rpd3Δ_2 | rpd3Δ_3 |
|---|---|---|---|---|---|---|---|---|---|---|---|---|---|---|---|
| Actin | – | – | – | – | – | – | – | – | – | – | – | – | – | – | – |
| Bud | – | – | – | – | – | – | – | – | – | – | – | – | 0 | 0 | 0 |
| Bud Neck | – | – | – | – | – | – | – | – | – | – | – | – | 0 | 0 | 0 |
| Bud Site | – | – | – | – | – | – | – | – | – | – | – | – | 0 | 0 | 0 |
| Cell Periphery | – | – | – | – | – | – | – | – | – | – | – | – | 0 | 0 | 0 |
| Cyto | – | – | – | – | – | – | – | – | – | – | – | – | – | – | – |
| Endoplasmic Reticulum | – | – | – | – | – | – | – | – | – | – | – | – | 0 | 0 | 0 |
| Endosome | – | – | – | – | – | – | – | – | – | – | – | – | 0 | 0 | 0 |
| Golgi | – | – | – | – | – | – | – | – | – | – | – | – | 0 | 0 | 0 |
| Mitochondria | – | – | – | – | – | – | – | – | – | – | – | – | 0 | 0 | 0 |
| Nuclear Periphery | – | – | – | – | – | – | – | – | – | – | – | – | 0 | 0 | 0 |
| Nuc | – | – | – | – | – | – | – | – | – | – | – | – | – | – | – |
| Nucleolus | – | – | – | – | – | – | – | – | – | – | – | – | 0 | 0 | 0 |
| Peroxisomes | – | – | – | – | – | – | – | – | – | – | – | – | 0 | 0 | 0 |
| SpindlePole | – | – | – | – | – | – | – | – | – | – | – | – | 0 | 0 | 0 |
| Vac | – | – | – | – | – | – | – | – | – | – | – | – | – | – | – |
| Cortical Patches | – | – | – | – | – | – | – | – | – | – | – | – | 0 | 0 | 0 |
| Cytoplasm | – | – | – | – | – | – | – | – | – | – | – | – | 0 | 0 | 0 |
| Nucleus | – | – | – | – | – | – | – | – | – | – | – | – | 0 | 0 | 0 |
| Vacuole | – | – | – | – | – | – | – | – | – | – | – | – | 12.5 | 12.5 | 12.7 |
External localization resources
Images






























Protein Concentration and Protein Localization Data
| R1 | R2 | R3 | ||||||||||||||||
|---|---|---|---|---|---|---|---|---|---|---|---|---|---|---|---|---|---|---|
| G1 Pre-START | G1 Post-START | S/G2 | Metaphase | Anaphase | Telophase | G1 Pre-START | G1 Post-START | S/G2 | Metaphase | Anaphase | Telophase | G1 Pre-START | G1 Post-START | S/G2 | Metaphase | Anaphase | Telophase | |
| Concentration | 1.0128 | 1.5309 | 1.1406 | 0.5418 | 0.8498 | 1.1798 | -0.3577 | -0.4296 | -0.3205 | -0.1603 | -0.5429 | -0.7016 | -1.1285 | -1.2126 | -1.3562 | -1.1393 | -1.199 | -1.0311 |
| Actin | 0.0292 | 0.0002 | 0.0053 | 0.0001 | 0.0316 | 0.0034 | 0.0267 | 0.001 | 0.0066 | 0.0125 | 0.0033 | 0.0071 | 0.0458 | 0.0004 | 0.0025 | 0.0129 | 0.0215 | 0.0091 |
| Bud | 0.0028 | 0.011 | 0.0017 | 0 | 0.0014 | 0.0006 | 0.006 | 0.0061 | 0.0079 | 0.0031 | 0.0007 | 0.0038 | 0.0019 | 0.0024 | 0.0001 | 0.0012 | 0.0016 | 0.0014 |
| Bud Neck | 0.0088 | 0.0001 | 0.0011 | 0 | 0.025 | 0.0022 | 0.0032 | 0.0003 | 0.003 | 0.0019 | 0.0011 | 0.0026 | 0.0056 | 0.0008 | 0.0001 | 0.0002 | 0.0011 | 0.0011 |
| Bud Periphery | 0.0056 | 0.002 | 0.0028 | 0 | 0.0038 | 0.0017 | 0.0119 | 0.01 | 0.0159 | 0.0151 | 0.0009 | 0.007 | 0.0049 | 0.0036 | 0.0002 | 0.0029 | 0.0035 | 0.002 |
| Bud Site | 0.0133 | 0.0104 | 0.0112 | 0 | 0.0071 | 0.002 | 0.0088 | 0.0177 | 0.027 | 0.006 | 0.0126 | 0.0022 | 0.0036 | 0.0203 | 0.0003 | 0.0012 | 0.0024 | 0.0005 |
| Cell Periphery | 0.0007 | 0.0003 | 0.0009 | 0 | 0.0003 | 0.0002 | 0.0008 | 0.0006 | 0.0009 | 0.0003 | 0.0002 | 0.0002 | 0.0004 | 0.0004 | 0 | 0.0001 | 0.0002 | 0.0001 |
| Cytoplasm | 0.0266 | 0.0234 | 0.0455 | 0.0314 | 0.0283 | 0.0797 | 0.0847 | 0.1078 | 0.1005 | 0.1158 | 0.129 | 0.1572 | 0.0291 | 0.0541 | 0.0219 | 0.0208 | 0.0129 | 0.0388 |
| Cytoplasmic Foci | 0.0151 | 0.0016 | 0.0073 | 0.0049 | 0.0298 | 0.0133 | 0.0186 | 0.0049 | 0.014 | 0.0414 | 0.0145 | 0.0099 | 0.0104 | 0.0042 | 0.0046 | 0.0032 | 0.0062 | 0.007 |
| Eisosomes | 0.0016 | 0.0002 | 0.0006 | 0.0001 | 0.0004 | 0.0003 | 0.0004 | 0.0001 | 0.0003 | 0.0004 | 0.0001 | 0.0001 | 0.001 | 0.0001 | 0.0002 | 0.0002 | 0.0002 | 0.0001 |
| Endoplasmic Reticulum | 0.0024 | 0.0004 | 0.0021 | 0.0003 | 0.0017 | 0.0004 | 0.0049 | 0.0011 | 0.0022 | 0.0019 | 0.0026 | 0.0008 | 0.003 | 0.0004 | 0.0009 | 0.0009 | 0.0047 | 0.0011 |
| Endosome | 0.0142 | 0.0001 | 0.0037 | 0.0005 | 0.015 | 0.004 | 0.0172 | 0.001 | 0.0056 | 0.0416 | 0.0259 | 0.0019 | 0.0164 | 0.0005 | 0.0019 | 0.0041 | 0.006 | 0.0047 |
| Golgi | 0.0067 | 0 | 0.0022 | 0.0005 | 0.0078 | 0.0022 | 0.0054 | 0.0001 | 0.0013 | 0.018 | 0.0073 | 0.0007 | 0.0035 | 0.0001 | 0.0014 | 0.0013 | 0.0024 | 0.0013 |
| Lipid Particles | 0.0133 | 0.0001 | 0.0094 | 0.0074 | 0.0043 | 0.0095 | 0.0108 | 0.0002 | 0.0017 | 0.0131 | 0.0261 | 0.0006 | 0.0037 | 0.0002 | 0.0024 | 0.0013 | 0.0011 | 0.0012 |
| Mitochondria | 0.0211 | 0.0003 | 0.0083 | 0.0002 | 0.0369 | 0.0018 | 0.0057 | 0.0005 | 0.0064 | 0.0193 | 0.029 | 0.0028 | 0.0018 | 0.0008 | 0.0018 | 0.0042 | 0.0026 | 0.0058 |
| None | 0.8059 | 0.9484 | 0.8676 | 0.9267 | 0.7609 | 0.8596 | 0.7419 | 0.8407 | 0.7831 | 0.6816 | 0.7247 | 0.7941 | 0.8424 | 0.9012 | 0.9537 | 0.9326 | 0.8985 | 0.9129 |
| Nuclear Periphery | 0.0045 | 0.0002 | 0.0017 | 0.0001 | 0.0038 | 0.0016 | 0.0132 | 0.0007 | 0.0051 | 0.0019 | 0.0063 | 0.0007 | 0.0067 | 0.0007 | 0.0026 | 0.0052 | 0.019 | 0.0033 |
| Nucleolus | 0.0015 | 0.0001 | 0.0009 | 0.0001 | 0.0044 | 0.0009 | 0.0026 | 0.0004 | 0.0035 | 0.0013 | 0.0012 | 0.0004 | 0.0014 | 0.0008 | 0.0002 | 0.0006 | 0.0002 | 0.0004 |
| Nucleus | 0.0023 | 0.0004 | 0.002 | 0.0002 | 0.0235 | 0.0011 | 0.0143 | 0.0025 | 0.0043 | 0.0024 | 0.0027 | 0.0018 | 0.0048 | 0.0019 | 0.0006 | 0.002 | 0.0023 | 0.0021 |
| Peroxisomes | 0.0178 | 0.0001 | 0.0211 | 0.0269 | 0.0052 | 0.0088 | 0.0091 | 0.0003 | 0.0016 | 0.0069 | 0.0041 | 0.0014 | 0.0018 | 0.0003 | 0.0017 | 0.0015 | 0.0102 | 0.0014 |
| Punctate Nuclear | 0.0038 | 0.0004 | 0.0029 | 0.0003 | 0.0037 | 0.0056 | 0.0056 | 0.0025 | 0.0045 | 0.0105 | 0.0039 | 0.0037 | 0.0069 | 0.006 | 0.0024 | 0.0025 | 0.0008 | 0.0048 |
| Vacuole | 0.0018 | 0.0002 | 0.0011 | 0.0001 | 0.0034 | 0.001 | 0.0063 | 0.0015 | 0.0039 | 0.0039 | 0.0025 | 0.0006 | 0.0041 | 0.0005 | 0.0003 | 0.0007 | 0.0013 | 0.0006 |
| Vacuole Periphery | 0.001 | 0 | 0.0005 | 0 | 0.0017 | 0.0002 | 0.002 | 0.0002 | 0.0008 | 0.0009 | 0.0015 | 0.0001 | 0.0008 | 0.0001 | 0.0002 | 0.0006 | 0.0013 | 0.0003 |
Sequencing Data
| R1 | R2 | |||||||||
|---|---|---|---|---|---|---|---|---|---|---|
| G1 Post-START | S/G2 | Metaphase | Anaphase | Telophase | G1 Post-START | S/G2 | Metaphase | Anaphase | Telophase | |
| Gene Expression | 1.3326 | 0.3971 | 3.2413 | 4.0906 | 2.5917 | 3.5517 | 3.4127 | 5.1487 | 3.8899 | 4.5343 |
| Translational Efficiency | – | – | – | – | – | – | – | – | – | – |
Hit Data
| Dataset | Hit |
|---|---|
| Protein Concentration | ✘ |
| Protein Localization | ✘ |
| Gene Expression | ✘ |
| Translational Efficiency | – |
Endocytosis
| Temp | Actin Patch (Sac6-tdTomato) | Cortical Patch (Sla1-GFP) | Late Endosome (Snf7-GFP) | Vacuole (Vph1-GFP) |
|---|---|---|---|---|
| 37℃ | ||||
| RT |
Cell Cycle Omics
CYCLoPs (Red1-GFP)
| Gene / Allele | Actin Patch (Sac6-tdTomato) | Cortical Patch (Sla1-GFP) | Late Endosome (Snf7-GFP) | Vacuole (Sac6-tdTomato) |
|---|
| Gene | Images |
|---|
| Gene | Images |
|---|
Images are not yet available
Images are not yet available